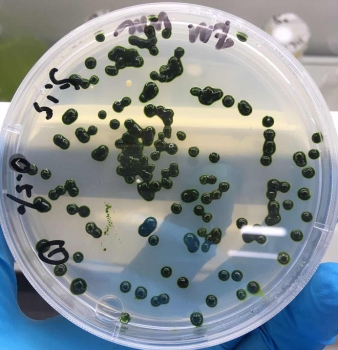
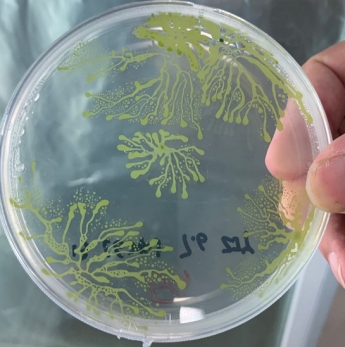

Dr. Jiangxin Wang, Professor, is a pioneering force inEuglenaresearch. His journey withEuglenabegan in 1996 as a graduate student at the Institute of Hydrobiology, Chinese Academy of Sciences, and it has been an unbreakable bond ever since. Over six years at the institute, he laid a strong academic foundation inEuglenastudies—setting the stage for decades of groundbreaking research.

Academic Journey
·1996:Embarked on graduate studies at the Institute of Hydrobiology, CAS, diving deep intoEuglenaresearch.
·2002:Expanded his expertise beyondEuglena, venturing to Paris, France, and Phoenix, USA, to explore other microalgae likeChlamydomonasandHaematococcus pluvialis, with a focus on bioenergy and high-value compounds.
·2014:Returned to Shenzhen, China, to establish theEuglenaResearch Laboratoryat Shenzhen University, continuing his relentless pursuit ofEuglenadiscoveries.
Research Focus
Professor Wang's research spans a vast spectrum ofEuglenastudies, including but not limited to:
·Algal Collection & Development:Gathering, isolating, purifying, and cultivatingEuglenastrains from nature and global algal repositories.

·Genomics:Successfully decoded and assembled theEuglena Zgenome at the chromosomal level (v1.0 published, v2.5 in progress).
·Light & Dark Adaptation:Investigating howEuglena Zresponds to different lighting conditions using multi-omics approaches.
·Mutant Strains & Genetic Engineering:Domesticating, mutagenizing, and genetically modifyingEuglenafor enhanced traits.
·Large-scale Production:Achieved industrial-scale cultivation ofEuglena Z, reaching fermentation dry weights of120 g/L, withparamylon exceeding 85%, and protein content hitting55%undermixotrophiccultivation conditions.


·Synthetic Biology:Leveraging RNAi and CRISPR-Cas9 to push the boundaries ofEuglena's synthetic biology applications.

One Life, One Alga
With an unwavering passion forEuglena, Professor Wang has rightfully earned the title of “EuglenaSuper Fan.” His lifelong dedication has not only propelledEuglenascience forward but also paved the way for its commercial applications. Under his leadership,Euglenaresearchin Chinais entering an exciting new era—one where science meets real-world impact.

Selected Publications
1.Yuan S, Fu W, Du M, Yao R, Zhang D, Li C, et al.Enhanced cold tolerance mechanisms inEuglena gracilis: comparative analysis of pre-adaptation and direct low-temperature exposure.Frontiers in microbiology2024, 15.
2.Chen Z, Dong Y, Duan S, He J, Qin H, Bian C, et al.A chromosome-level genome assembly for the paramylon-producing microalgaEuglena gracilis.Sci Data2024, 11(1):780.
3.Zixi Chen YC, Hua Zhang, Huan Qin, Jiayi He, Zezhou Zheng, Liqing Zhao, Anping Lei, Jiangxin Wang. Evaluation ofEuglena gracilis815 as a new candidate for biodiesel production.Frontiers in Bioengineering and Biotechnology-Bioprocess Engineering2022.
4.Zhenfan Chen, Zixi Chen, Jiayi Zhu, Jiayi He, Qiong Liu, Hui Zhu, et al.Proteomic responses of dark-adaptedEuglena gracilisand bleached mutant against light stimuli.Frontiers in Bioengineering and Biotechnology-Bioprocess Engineering2022, 2022:843414.
5.Zhenfan Chen, Jiayi Zhu, Du M, Zixi Chen, Qiong Liu, Hui Zhu, et al.A Synthetic Biology Perspective on the Bioengineering Tools for an Industrial Biotechnology Platform:Euglena gracilis.Frontiers in Bioengineering and Biotechnology-Bioprocess Engineering2022, 882391.
6.Yao R, Fu W, Du M, Chen Z, Lei A, Wang J. Carotenoids biosynthesis, accumulation, functions, and applications of a model microalgaEuglena gracilis.Marine Drugs2022.
7.Wu MC, Wu GM, Lu FM, Wang HX, Lei AP, Wang JX. Microalgal photoautotrophic growth induces pH decrease in the aquatic environment by acidic metabolites secretion.Biotechnology for Biofuels and Bioproducts2022, 15(1).
8.He J, Du M, Chen Y, Liu Y, Zhang JK, Fu W, et al.Fatty acid accumulations and transcriptome analyses under different treatments in a model microalgaEuglena gracilis.Frontiers in Chemical Engineering2022, 884451.
9.Gao W, Jamwal DR, Wang J, Xu H. Single Cell Analysis -Discovery, Development and Implications to Study Cell-Cell and Cell-Pathogen Interactions.Frontiers in Cell and Developmental Biology Signaling2022, 22:951506.
10.Dai J, Jiayi He, Zixi Chen, Qin H, Du M, Lei A, et al.Euglena gracilispromotes Lactobacillus growth and antioxidants accumulation as a potential next generation prebiotic.Frontiers in Nutrition Nutrition and Microbes2022:864565.
11.Chen Z, Zhu J, Chen Z, Du M, Yao R, Fu W, et al.High-throughput sequencing revealed low-efficacy genome editing using Cas9 RNPs electroporation and single-celled microinjection provided an alternative to deliver CRISPR reagents intoEuglena gracilis.Plant Biotechnol J2022.
12.Chen Z, Mo B, Lei A, Wang J. Microbial single-cell analysis: what can we learn from mammalian?Frontiers in Cell and Developmental Biology Signaling2022.
13.Xie Y, Li J, Qin H, Wang Q, Chen Z, Liu C, et al.Paramylon fromEuglena gracilisprevents lipopolysaccharide induced acute liver injury.Front Immunol2021.
14.Wu M, Qin H, Deng J, Liu Y, Lei A, Zhu H, et al.A new pilot-scale fermentation mode enhancesEuglena gracilisbiomass and paramylon (β-1,3-glucan) production.Journal of Cleaner Production2021:128996.
15.Wu M, Du M, Wu G, Lu F, Li J, Lei A, et al.Water reuse and growth inhibition mechanisms for cultivation of microalgaEuglena gracilis.Biotechnology for biofuels2021, 14(1):132.
16.Ouyang Y, Chen S, Zhao L, Song Y, Lei A, He J, et al.Global metabolomics reveals that Vibrio natriegens enhances the growth and paramylon synthesis ofEuglena gracilis.Front Bioeng Biotechnol - Bioprocess Engineering2021.
17.Li J, Zheng Z, Du M, Chen J, Zhu H, Hu Z, et al.Euglena gracilisand its aqueous extract constructed with chitosan-hyaluronic acid hydrogel facilitate cutaneous wound healing in mice without inducing excessive inflammatory response.Front Microbiol - Microbiotechnology2021.
18.He J, Liu C, Du M, Zhou X, HU Z, Lei A, et al.Metabolic responses of a model green microalgaEuglena gracilisto different environmental stresses.Frontiers in Bioengineering and Biotechnology-Bioprocess Engineering 2021, 10.3389/fbioe.2021.662655.
19.Wu M, Li J, Qin H, Lei A, Zhu H, Hu Z, et al.Pre-concentration of microalgaEuglena gracilisby alkalescent pH treatment and flocculation mechanism of Ca(3)(PO(4))(2), Mg(3)(PO(4))(2), and derivatives.Biotechnology for biofuels2020, 13:98.
20.Qin H GQ, Liu CC, Li FL ZHang H, Chu ZH, Wang J, Lei AP. Occurrence and light response of residual plastid genes in aEuglena gracilisbleached mutant strain OflB2.Journal of Oceanology and Limnology2020, 38(1-2).
21.Guo Q, Bi D, Wu M, Yu B, Hu L, Liu C, et al.Immune activation of murine RAW264.7 macrophages by sonicated and alkalized paramylon fromEuglena gracilis.BMC microbiology2020, 20(1):171.
22.Shao Q, Hu L, Qin H, Liu Y, Tang X, Lei A, et al.Metabolomic response ofEuglena gracilisand its bleached mutant strain to light.PloS one2019, 14(11):e0224926.
23.邵青蒋,雷安平,胡章立,王江新.裸藻遗传转化技术的研究进展.水生生物学报2018, 42(3):655-662.
24.JX W, ZX S, XD X. Residual plastids of bleached mutants of Euglena gracilis and their effects on the expression of nucleus-encoded genes.Prog Nat Sci 2004, 3:21-25.
25.王江新,施之新,徐旭东.纤细裸藻褪色突变株的残留质体及其对核基因表达的影响.自然科学进展2003, 9.
26.王江新,施之新,徐旭东.两种裸藻的无叶绿体突变株.水生生物学报2002, 2.
27.王江新.裸藻质体在竞争和适应中的作用.中国科学院水生生物研究所, 2002.
28.施之新王谢钟潘.一种改进的快速有效的裸藻DNA抽提方法.水生生物学报1999.